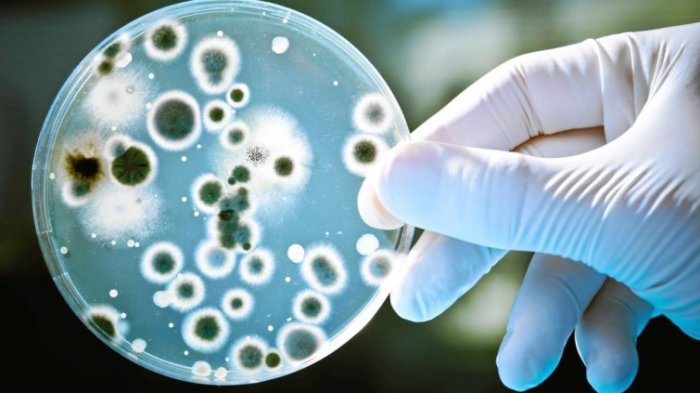

TRIBUNTRAVEL.COM - Jutaan penduduk Eropa, Amerika Utara, dan Australia terancam infeksi bakteri super yang kebal terhadap berbagai jenis obat-obatan.
Peringatan tersebut dilayangkan oleh Organisasi Kerjasama Pembangunan Ekonomi Eropa (OECD), Rabu (7/11/2018).
OECD mewanti-wanti wabah bakteri super bisa menyebabkan konsekuensi buruk pada kesehatan publik dan anggaran kesehatan.

• Produk Masker dari China Ditemukan Mengandung Steroid & Bakteri Berlebih, Penggunanya Alami Bengkak
Organisasi itu menuntut agar pemerintah di sejumlah negara memperbaiki standar kebersihan di rumah sakit dan mengurangi penggunaan antibiotika pada pasien.
Menurut studi teranyar, sebanyak 33.000 orang Eropa meninggal dunia pada 2015 akibat bakteri yang kebal obat-obatan.
Dalam laporannya, OECD memprediksi korban jiwa akibat bakteri super pada 2050 bisa mencapai 2,4 juta orang.
Adapun anggaran yang diperlukan untuk meredam wabah tersebut akan berada di kisaran 3,5 triliun euro untuk setiap negara.
OECD mengklaim, Indonesia termasuk negara yang paling rajin mengonsumsi antibiotika untuk keperluan medis atau untuk kesehatan hewan di sektor peternakan.
• Keju Tertua di Dunia yang Ditemukan di Makam Mesir Ternyata Berisi Bakteri Berbahaya Bagi Manusia
Akibatnya, muncul jenis bakteri baru yang kebal terhadap obat-obatan yang didesain untuk membunuhnya.
Bersama Brasil, China dan Rusia, saat ini 60 persen infeksi bakteri di Indonesia dinyatakan kebal terhadap (setidaknya) satu jenis antibiotika.
Fenomena resistansi antibiotik alias AMR ini dikhawatirkan akan semakin mengancam jika tidak ditanggulangi komprehensif.
"Penanggulangan AMR biayanya lebih mahal ketimbang penyakit flu, HIV, atau tuberkulosis," kata Direktur Kesehatan Publik OECD Michele Cechhini.
• 5 Alasan Harus Hentikan Kebiasaan Bawa Ponsel ke Toilet, Banyak Bakteri dan Kuman!
Dalam laporannya, OECD hanya fokus menganalisis ancaman AMR di negara-negara Uni Eropa, namun turut menggunakan data kesehatan negara anggota G20 seperti Indonesia.
"Resistansi tinggi akan menciptakan kondisi yang bisa berujung pada angka kematian tinggi," begitu bunyi laporan setebal lebih dari 200 halaman tersebut.
"Akibatnya, bahkan luka kecil akibat tersayat pisau di dapur, operasi kecil, atau penyakit seperti pneumonia bisa mengancam nyawa." OECD meyakini laju peningkatan infeksi AMR akan bertambah empat sampai tujuh kali lipat lebih cepat pada 2030.
• 7 Kuliner Malam Enak dan Murah di Bandung, Tidak Membuatmu Kantongmu Menipis
AMR memang merupakan fenomena alami yang kerap muncul akibat perubahan genetika.
Namun, penggunaan berlebih antibiotika bisa mempercepat proses tersebut.
Oleh karena itu, Badan Kesehatan Dunia (WHO) mewanti-wanti penduduk agar menolak antibiotika tanpa arahan jelas dari dokter.
• Viral Driver Ojek Online Mendapat Tiket Gratis Gun N Roses di Stadion Utama Gelora Bung Karno
Pasien juga dianjurkan tidak mengonsumsi antibiotik sisa milik pasien lain.
Peringatan muram OECD bukan yang pertama terkait ancaman AMR.
Pada 2016 silam, studi yang dibuat ekonom Inggris, Jim O'Neill, sampai pada kesimpulan bahwa kegagalan dalam menangani AMR akan menyebabkan 10 juta kematian setiap tahun dan diyakini bakal menyedot biaya hingga 100 triliun dollar AS pada 2050.
• 4 Kuil Paling Misterius di India, Ada Pintu Rahasia yang di Kuil Shree Padmanabhaswamy
Artikel ini telah tayang di Kompas.com dengan judul "Kebal Antibiotik, Bakteri Super Bakal Bunuh Jutaan Manusia pada 2050".